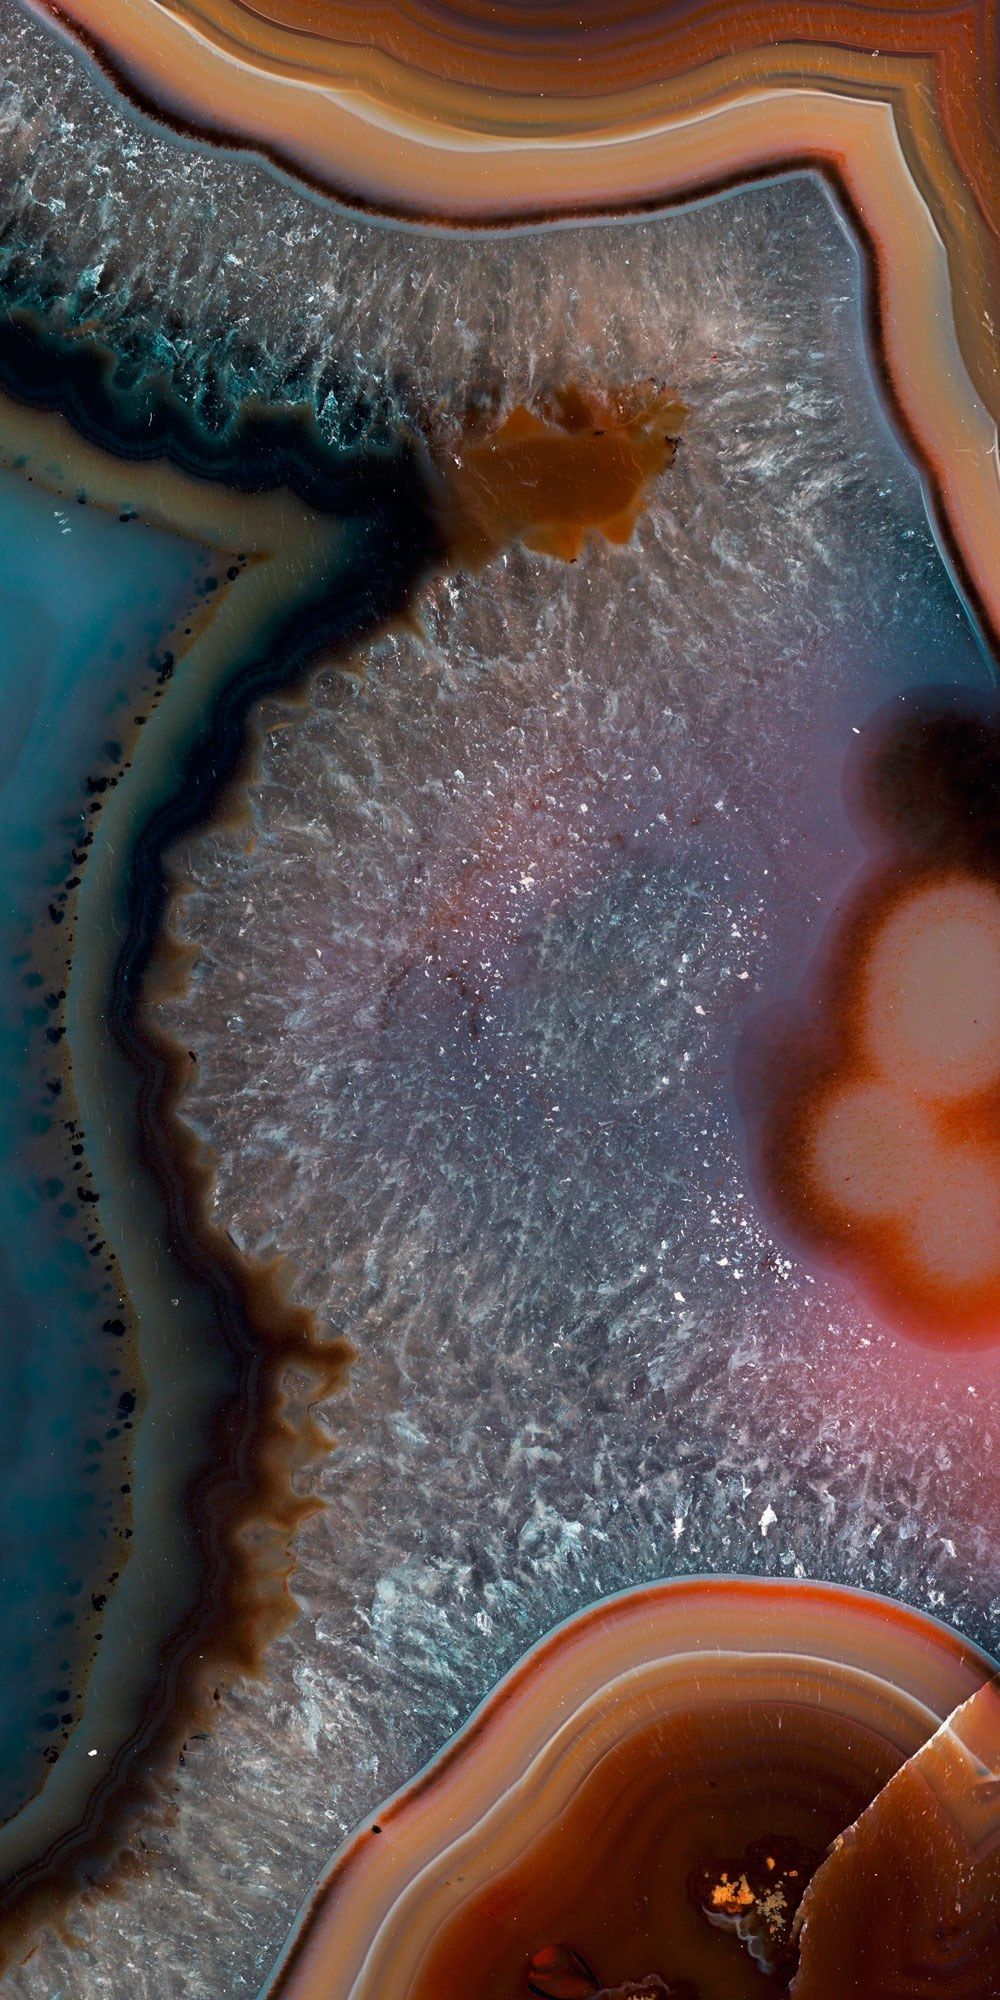
Декоративная панель из алюминия, стекла или ПММА Tecnografica драгоценные камни ARCH-00089120 - Вид №3

Внимание: Santreyd — информационный посредник. Товары представлены в рамках параллельного импорта. Изображения и описания носят информационный характер.
+7 (485) 260-70-14

Ваш городЯрославль
Каталог товаров